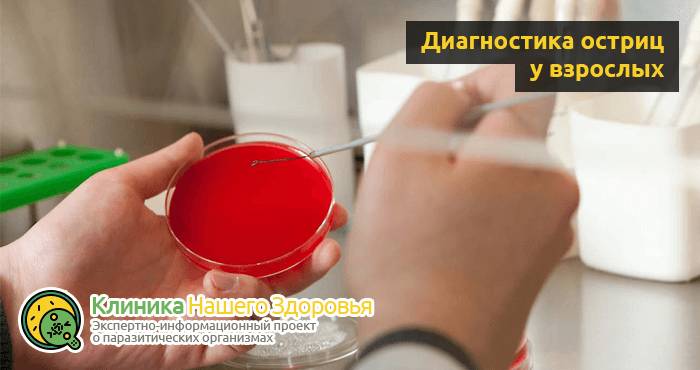
ostricy-u-vzroslyx-7.png

Человека с самого первого мгновения жизни в большом и далеко не дружелюбном мире подстерегают тысячи опасностей и сотни врагов.
Некоторые совсем незаметные невооруженному глазу (например, микробы и вирусы), некоторые огромные вроде хищных зверей, а некоторые с виду не представляющие никакой угрозы, но не менее опасные, чем зубастый тамбовский волк это паразиты и глисты. И главная опасность их в том, что вредят они изнутри организма.
Как вы уже наверное поняли, разговор пойдет о паразитах, в частности паразитических червях (гельминтах), заражающих человека и наносящих огромный вред организму. Одним из представителей такого рода паразита являются острицы.
Острицы являются наиболее известными и самыми распространенными паразитами, способными поразить кишечную микрофлору человека. Гельминты при размножении вызывают заболевание, именуемое энтеробиоз. В народе это заболевание носит более понятное название: болезнь грязных рук.
Острицы род червей из семейства оксиурид, паразитирующих в пищеварительной системе человека. Они являются причиной энтеробиоза. Это один из самых известных и распространенных паразитов человека.
Неудивительно, что наиболее уязвимыми к заражению острицами считаются дети, в особенности школьного и дошкольного возраста, в частности, посещающие учреждения массового характера. Сам процесс заражения происходит достаточно просто: стоит, к примеру, пожать руку зараженному человеку и появится еще один пациент. Поэтому, энтеробиоз чаще всего передается контактно-бытовым путем, независимо от возраста человека.
Чтобы вовремя предотвратить возможные последствия, в первую очередь нужно знать какие существую признаки остриц у взрослых людей.
Что представляют из себя острицы
Как уже было сказано, острица (гострики) это червь. Согласно зоологической классификации относится к роду нематод (круглые черви. Из всего многообразия нематод, далеко не все являются паразитами, есть и вполне безобидные виды, населяющие и сушу и водное пространство).
Острица (гострики) представитель червей, ведущих паразитический образ жизни. Страдают от нее не только люди, но и человекообразные обезьяны. Вызывают заболевание под названием энтеробиоз. Острицы встречаются как у детей (даже у грудничка), так и у взрослых (у женщин и мужчин).
Внешне представляют из себя вытянутое цилиндрообразное тело длинной от 0,2 до 1,5 см серо-белого цвета, диаметр уменьшается ближе к концам тела. Данный вид представлен разнополыми особями. Обитают в тонком кишечнике и слепой кишке. Оплодотворение происходит в подвздошной кишке, после чего самцы погибают, а самка, наполненная яйцами через анальное отверстие проникает на поверхность тела, где откладывает яйца и тоже погибает. Цикл жизни не превышает месяца.
Как только самка будет оплодотворена, самец острицы погибает и выводится наружу вместе с фекалиями, но заметить самца остриц в кале довольно тяжело, так как он частично разлагается. Тем временем самка продолжит жить в кишечнике еще около месяца, после чего направится в прямую кишку и выйдет через анальное отверстие для кладки яиц.
Основной вред, приносят токсичные продукты жизнедеятельности паразитов, вызывающие нарушения в работе кишечника, повышенную утомляемость. Также при размножении острицы оказывают сильное раздражающие воздействие на кожу в районе прианальных складок и в паховой области. В запущенных стадиях могут вызвать тяжелые заболевания внутренних (в том числе половых) органов.
Яйца паразита могут находиться на одежде, постельном и нижнем белье, а также предметах общего пользования, в том числе на поручнях в общественных местах. После попадания в желудок, яйца остриц активируются и из них выбираются маленькие личинки, которые на протяжении пары недель развивают до половозрелых особей.
Как правило, самка острицы выходит для кладки яиц в ночное время суток, но при большом их количестве возможен выход наружу и в дневное время. Здесь ей необходимо добраться до складок кожи, обычно это задняя промежность и половые органы, где наиболее подходящая температура для потомства.
За один раз самка откладывает около 10-15 тысяч яиц, закрепляя кладки к коже при помощи специальной жидкости. Яйцам остриц необходимо несколько часов, чтобы стать инвазионными. Соответственно, они могут вновь поражать своего же хозяина или передаваться другим людям.
Заметьте, что острицы во время выхода наружу вызывают зуд и небольшое жжение, что провоцирует занос яиц под ногти.
Врачи отмечают, что заражение острицами, или энтеробиоз, является распространенной проблемой, особенно среди детей. Эти паразиты передаются через контакт с зараженными поверхностями или предметами, а также через грязные руки. Симптомы включают зуд в области ануса, что может привести к беспокойству и нарушению сна. Врачи подчеркивают важность соблюдения гигиенических мер, таких как регулярное мытье рук и стирка постельного белья. При подозрении на заражение рекомендуется обратиться к специалисту для диагностики и назначения эффективного лечения. Своевременное вмешательство позволяет избежать осложнений и предотвратить распространение инфекции в семье и коллективе.
https://youtube.com/watch?v=4Gu4ulYaOSQ
Цикл жизни личинок острицы в человеческом организме
Независимо от организма, будь то взрослый или ребенок, личинка, попавшая через рот в организм, начинает стадии своего существования. Первоначально, под воздействием ферментов пищеварительных желез идет разрушение оболочки яиц. Личинка освобождается от оболочки. Попав в отделы кишечника, личинка развивается до своего полного становления в среднем за 2-3 линьки. После чего особи разных полов спариваются. Самцы после процесса оплодотворения становятся неактивными и погибают, выходя вместе с каловыми массами. Самка, благодаря своей способности закрепляться, присасывается к стенке кишечника для выноски яиц. Одна самка может отложить от 5 до 17 тысяч личинок за один раз. Как только особь отложила яйца, она погибает. Увидеть её невооруженным глазом невозможно, так как её тельце высыхает.
Как выглядят острицы?
По описанию, это черви белого цвета. Форма тельца веретенообразная, отличается в зависимости от пола глиста. Так, у самки гельминта конец тельца заострен. Самец же имеет хвост в форме крючка. Длина тела самки колеблется от 9 до 12 мм, что в разы превосходит самцов, их длина составляет всего от 3 до 5мм.
Паразиты имеют достаточно упрощенную систему пищеварения, состоящую из рта, непосредственно самого пищевода, переходящего в кишечник и анальное отверстие, выводящее продукты распада.
К сравнению, половая система остриц устроена гораздо сложнее. У самок она представлена вульвой, влагалищем, маткой и яичниками. Самцы имеют семенник, завершенный спикулой, выводящей сперматозоиды.
Заражение острицами, или энтеробиоз, вызывает множество обсуждений среди людей. Многие делятся своим опытом, отмечая, что это довольно распространенная проблема, особенно среди детей. Симптомы, такие как зуд в области ануса, могут вызывать дискомфорт и беспокойство. Некоторые родители рассказывают, как их дети страдали от бессонницы из-за этого недуга, что добавляло стресса в повседневную жизнь.
Люди также обсуждают методы лечения, включая использование специальных препаратов и соблюдение гигиенических мер. Важно отметить, что многие подчеркивают необходимость регулярной профилактики, особенно в семьях с маленькими детьми. Обсуждения часто касаются и стереотипов, связанных с этой проблемой, когда некоторые считают, что заражение острицами связано только с плохой гигиеной, хотя это может произойти и в самых чистых домах. В целом, тема остается актуальной, и многие ищут информацию, чтобы лучше понимать и предотвращать заражение.
https://youtube.com/watch?v=IczIGmDWLoU
Фото остриц
Острицы это мелкие круглые черви. На фото видно, что их размер 2-5 мм (самцы) и 9-12 мм (самки). По форме напоминают тонкие белые палочки с заостренными концами. Эти паразиты обитают преимущественно в толстом кишечнике, иногда заходят в конечные отделы тонкого.
Взрослые самки выползают из заднего прохода для того, чтобы отложить яйца. Именно там оптимальная среда для созревания температура около 37 С и высокая влажность. Яйца становятся заразными через 4-6 часов. Этот процесс обуславливает основной симптом заболевания зуд.
Чем опасен энтеробиоз последствия заболевания
Если человеку кажется, что такое маленькое существо, как острица не может нанести огромный вред организму, то это мнение можно опровергнуть:
- Присутствие червя в организме приводит к нарушению целостности кишечной слизистой. Острицы очень быстро размножаются, значит, кишечник пострадает достаточно серьезно и потребуется дополнительное лечение.
- Добравшись до слепой кишки, паразиты вызывают ее воспаление, что во многих случаях заканчивается приступом острого аппендицита. Лечение придется проводить хирургическим путем.
- Любая жизнедеятельность происходит с выделением вредных веществ в окружающее пространство. Так и гельминты в процессе своей жизни засоряют человеческий организм продуктами распада. Человек испытывает признаки интоксикации: появляется аллергия, часто болит голова, беспокоит слабость и головокружение, присоединяется тошнота.
- Паразиты приводят к подрыву иммунной системы человека. Ослабленный организм не в состоянии противостоять вирусам и инфекциям.
- У женщин острицы заползают в половые органы, проникнув в матку или маточные трубы, черви провоцируют обильные выделения из них. Вульвовагинит также может быть вызван присутствием паразитов во влагалище.
- Детский организм при заражении острицами страдает от авитаминоза, ведь паразиты все питательные вещества забирают себе.
Не закрывайте глаза на заражение паразитами, они приносят сильнейшие осложнения, если яйца вовремя не обезвредить. Осложнения могут произойти из-за ранок, появляющиеся при расчесывании. Бактериальное заражение происходит быстро, развивая дерматиты. При худшем исходе проявляется раздражение брюшины, пиодермия, парапроктит, сфинктерит. Аналогичные болезни проявляются при полном глубоком погружении червей в стенки брюшной полости. Энтеробиоз также передает другие заболевания (лямблии).
Появление гельминтов приводит к чрезмерной активности секреторных желез. Как следствием появления остриц в организме может являться развитие энтеритов.
Ученые выяснили, что паразиты сильно изменяют микробиоценоз организма, вследствие чего почти у всех зараженных развивается дисбактериоз.
Из-за токсичных выделений гельминтов человеческий организм подвержен отравлению. Именно поэтому у дошкольников заболевание проходит хуже, чем у взрослых. А для мам, ожидающих младенца, паразиты оборачивается тяжелым токсикозом. Также острицы снижают общий иммунитет, вследствие чего человек подвержен другим вирусам.
Могут ли острицы вызывать заболевание внутренних органов
Хроническая форма энтеробиоза без должного лечения становится причиной нарушения функций различных внутренних органов и систем. Острицы могут провоцировать:
- заболевания мочеполовой системы;
- аллергии;
- расстройства нервной системы;
- нарушать функции желудочно-кишечного тракта;
- ослабление общего иммунитета;
- негативно сказаться на физическом, умственном развитии ребенка.
От заражения острицами никто не застрахован, однако соблюдение профилактических мер помогут значительно снизить вероятность инвазии. При появлении первых симптомов заражения лучше обратиться к врачу для оказания адекватных медикаментозных методов терапии. Самолечение может значительно усугубить проблему, привести к непоправимым последствиям.
https://youtube.com/watch?v=w6-RT6tABP8
Причины заражения
Яйца паразитов в организм человека попадают через рот. В кишечнике из них выходят личинки, которые растут и превращаются в половозрелые особи. Они спариваются, самка через 4 недели выползает из заднего прохода и откладывает яйца, при этом сама погибает. Круг замыкается. Рассмотрим способы заражения подробнее:
- При расчесывании кожи яйца попадают под ногти, затем происходит самозаражение (достаточно один раз поесть, не вымыв руки).
- Если встряхнуть постельное белье, на котором есть частицы гельминтов, они поднимаются в воздух и могут быть проглочены человеком с пылью.
- При рукопожатии через грязные руки.
- Через обсемененные бытовые предметы (дверные ручки, пульт телевизора, столовые приборы, детские игрушки, одежду).
- Вместе с обсемененными продуктами, которые недостаточно вымыты проточной водой.
- Если после ухода за больным ребенком взрослый не моет руки.
- Употребление пищи, обсемененной мухами и другими насекомыми.
- Через шерсть домашних животных, которые сами не болеют, но могут переносить частицы гельминтов.
Предрасполагают к заражению некоторые вредные привычки: питание на ходу (за компьютером, телевизором), непостоянное мытье рук после общения с домашними животными или посещения туалета. Длинные ногти у женщин тоже облегчают сохранение яиц паразитов на руках и последующее их проглатывание. Самозаражение основной механизм поддержания постоянной колонии гельминтов в кишечнике. Если его не происходит, человек выздоравливает даже без лечения через несколько недель.
Кто подвержен заражению
Большинство заболевших энтеробиозом дети. В результате отсутствия сложившихся навыков соблюдения личной гигиены именно они чаще всего являются переносчиками гельминтоза. В детском коллективе, где все пользуются общими игрушками, заразившийся острицами ребенок становится источником инфекции для здоровых малышей. В группу риска входят владельцы и заводчики кошек, собак. В меньшей степени подвергаются заражению взрослые. Причина заболевания энтеробиозом та же пренебрежение правилами гигиены, отсутствие привычки мыть руки.
Чаще всего дети заражаются острицами
Как происходит заражение острицами у взрослых
Для предотвращения заболевания нужно отчетливо понимать, откуда берутся острицы и как они распространяются. Источником глистной инвазии является человек. Пути заражения связаны с грязными руками, через которые они попадают в организм при приеме пищи. При расчесывании промежности во время сна яйца остриц попадают на руки, а после — на белье, одежду, дверные ручки, предметы мебели.
Оттуда цисты остриц передаются другим людям. Также можно заразиться, вдыхая пыль, поскольку яйца остриц сохраняют свою жизнеспособность в окружающей среде на протяжении трех недель.
Активными разносчиками паразитов являются тараканы и мухи, поэтому от них нужно избавляться радикальным способом. Шерсть домашних животных может собирать цисты этих гельминтов, так что острицы могут попасть внутрь организма и от кошки.
Острицы это глисты, паразитирующие исключительно в организме человека, который является их единственным хозяином.
Для заражения острицами, человеку необходимо занести в организм сразу большое количество инвазионных яиц, поскольку с уничтожением небольшого числа яиц, организм может справиться еще в желудке.
Оказавшись в желудке, яйца остриц активируются и из них выходят личинки, которые проникают в тонкий кишечник, где питаются полезными веществами и развиваются до половозрелого возраста. Далее развитие энтеробиоза проходит в следующем порядке:
- Через 2-4 недели острицы становятся половозрелыми, самка оплодотворяется, а самец погибает;
- Еще пару недель самка вынашивает потомство, обычно срок не превышает 1 месяца;
- При созревании яиц, самка отцепляется от кишечника и направляется к прямой кишке. Часто острицы выходят из организма вместе с фекалиями ранним утром, их заметно, так как они ползают по калу;
- За один раз самка может отложить до 10-15 тысяч яиц и на этой стадии они не представляют опасности для человека;
- Яйца крепятся к кожным складкам, им необходима определенная влажность и тепло, в идеальных условиях яйца становятся инвазионными через четыре часа, то есть к утру, когда возникает зуд на коже;
- После кладки яиц самка погибает и может быть замечена на постельном или нижнем белье;
- Утром у человека появляется зуд, он расчесывает участок с прикрепленными яйцами остриц. Если, не помыв руки, он отправляется за стол, то вновь поглощает яйца и процесс развития глистной инвазии повторяется;
Важно понимать, что помимо себя, человек с острицами может заражать всех окружающих. Поэтому, в случае обнаружения остриц у человека, они с большой вероятностью будут присутствовать у всех остальных членов семьи или сожителей.
Многие люди считают, что если для полноценного развития острицам необходимы особые температурные условия, то вдали от организма человека они быстро погибают и не представляют какой-либо опасности. Но такое мнение крайне неверно, поскольку оказавшись на постельном белье, поручне, игрушках или иных предметах, яйца остриц остаются жизнеспособными еще как минимум три недели.
Но поскольку яйца остриц не имеют возможности самостоятельного передвижения, заражение энтеробиозом обычно происходит исключительно по вине человека, который не соблюдает правила личной гигиены, например, не помыл руки перед едой.
Острицы могут передаваться грудным детям. Малыш, начинающий ползать самостоятельно активно стремится познать окружающий мир, перемещаясь по квартире. При этом он тянет все, что попадает под руку, в том числе предметы и игрушки, на которых могут находиться яйца глист. Для ребенка первого года жизни заражение острицами особенно опасно. Заболевание может перейти в хроническую стадию, лишая неокрепший детский организм необходимых питательных веществ. При обнаружении у ребенка признаков энтеробиоза, рекомендуется немедленно обратиться к врачу, чтобы установить точный диагноз и вовремя начать лечение.
Возможна передача остриц при тесном общении с домашним питомцем. После прикосновения к кошке или собаке руки необходимо мыть с мылом. На шерсти животного яйца остриц сохраняют свою способность к жизнедеятельности до трех недель. При поглаживании питомца они оказываются на руках, после чего попадают в рот.
Инфицироваться можно через воздух, где яйца паразитов оказываются при встряхивании постельного белья или одежды.
Заражение острицами часто происходит в общественных местах, особенно в транспорте, при посещении бассейна, спортивного зала. Защитить себя от энтеробиоза можно только соблюдая правила гигиены, предусматривающие обязательное мытье рук перед едой и после посещения туалета.
От чего появляются острицы у взрослых
Повторное самозаражение
Если взрослый человек уже заражен острицами, он может инфицироваться от самого себя при расчесывании заднего прохода и промежности, на которой находятся яйца остриц. Зачастую после такого расчесывания, человек сам того не замечая прикасается руками ко рту или различным предметам, которые в итоге могут оказаны во рту (например, столовые приборы, пишущие принадлежности и пр.).
Непроизвольное проглатывание яиц гельминта
Например, во время встряхивания постельного белья, когда яйца гельминтов поднимаются в воздух и непроизвольно попадают в организм при дыхании. Подобный вариант заражения острицами у взрослых возможен даже при нахождении в одном помещении с уже зараженным человеком.
Заражении при бытовом контакте
Очень часто, развитие остриц у взрослых людей происходит в результате рукопожатий, прикосновений или при простом похлопывании по одежде.
Инфицирование в общественных местах
Не менее редко встречается заражение при прикосновении с предметами общего пользования, дверными ручками, поручнями и иными предметами в общественных местах, где может быть большое количество больных энтеробиозом.
Перенос яиц от насекомых
Яйца остриц иногда переносятся тараканами и мухами, а также другими насекомыми. Причем им необязательно ползать исключительно по еде, опасными для заражения местами может быть стол, различные покрытия и даже посуда.
Заражение от домашних животных
Очень часто яйца паразита встречаются на шерсти домашних животных, куда они попадают вместе с пылью. Если человек играет с животным и не моет руки, то риск заражения огромен как у взрослых, так и у детей.
В результате не соблюдения личной гигиены
Как отмечают врачи, риск заражения гельминтами всегда выше у тех, кто имеет длинные ногти на руках, так как под ними всегда скапливается грязь и различные микробы, в том числе яйца различных паразитов. Особенно высок риск заражения острицами у взрослых, если они грызут свои ногти или ороговевшую кожу.
Симптомы инвазии
Подозрение на заражение человека острицами можно определить с помощью внешних симптомов (см. фото выше):
- непрекращающийся или периодически повторяющийся зуд в районе анального отверстия в вечернее и ночное время;
- беспокойный сон, особенно у детей (в том числе возможен скрежет зубами);
- расстройства кишечника;
- боль в животе и слюноотделение;
- повышенная утомляемость.
Проявление внешних симптомов заражения острицами могут сильно отличатся у детей и взрослых. У детей проявления более яркие и заметные, тогда, как острицы у взрослых могут вызывать мало заметный дискомфорт, которому зачастую не придают значения.
Важно помнить, что внешние признаки, похожие не симптомы острицы не всегда свидетельствуют о заражении, но при их появлении необходимо срочно сдать все необходимые анализы, чтобы своевременно начать лечение.
Признаки заболевания у взрослых
При наличии остриц у взрослых, первые признаки энтеробиоза появляются спустя две недели после момента инфицирования.
При этом важно понимать, что глисты могут вызывать индивидуальные симптомы, так, у одних людей симптоматика будет ярко выраженной, в то время как у других людей, признаки инвазии могут полностью отсутствовать. В связи с чем, выявить остриц у взрослых иногда бывает затруднительной, лечение затягивается и происходит постоянное заражение окружающих людей.
Часто симптомы остриц у взрослых путают с проблемами ЖКТ или аллергией. Неправильные диагнозы затягивают лечение, увеличивая шансы заражения близких людей.
Симптоматика энтеробиоза у взрослых может выражаться следующими признаками:
- Самый характерный признак для энтеробиоза зуд в области анального отверстия, беспокоящий в ночное время. Зуд может длиться несколько ночей подряд, а затем затихать на пару недель. В это время происходит созревание личинки и переход в половозрелую стадию. Буквально через 15-20 дней оплодотворенные самки снова спускаются из кишечника, чтобы отложить яйца вокруг ануса, человек в это время отмечает повторное появление зуда.
- Глисты приводят к расстройству пищеварительного процесса. Могут возникать диареи и запоры.
- Боль в животе и тошнота очень часто свидетельствуют об интоксикации организма. При глистной инвазии этот симптом возникает у всех зараженных.
- Возникают лже-позывы к дефекации, которые не приводят к опорожнению кишечника.
- Интоксикация приводит к появлению головных болей.
- Глисты высасывают все соки из организма. Человек начинает резко сбрасывать вес. Может понижаться аппетит.
- Хроническая усталость, постоянное депрессивное состояние, чрезмерная раздражительность все эти симптомы характерны для глистной инвазии.
- Аллергические реакции организма на паразитов, кожные высыпания, зуд, жжение по всему телу и покраснения. Помимо этого, иногда, когда болезнь сильно затягивается, а лечение не проводится, возможны приступы удушья и лихорадка.
- Воспалительные процессы вокруг анального отверстия, порой в промежности и на половых органах. В этом случае острицы в большом количестве выползают наружу и откладывают яйца повсюду. Такой симптом особенно опасен для женщин, так как с присоединением вторичной инфекции могут развиваться женские болезни вплоть до бесплодия.
- При наличии остриц, взрослый человек может начать страдать недержанием мочи. Чаще всего это происходит в ночное время суток, но внезапное желание посетить туалет возможно и днем. Связано это с воспалительными процессами в мочеполовой системе.
Как показывает практика, если взрослый человек заразился острицами вне семьи, например, после рукопожатия, при этом человек соблюдает правила гигиены, часто моет руки перед едой, ежедневно меняет нижнее белье, принимает душ, а также своевременно меняет постельное белье, то в этом случае, симптомы энтеробиоза могут вообще не проявляться. Кроме того, в данном случае возможно и не понадобится лечение, так как паразиты сами погибнут через несколько недель.
Энтеробиоз у детей
Родители должны внимательно присматриваться к своим детям.
Если были замечены хотя бы 2 пункта из нижеизложенных, следует пройти диагностику на выявление гельминтоза:
- Периодическая боль в животе. Обычно маленькие дети не могут точно указать локализацию болезненности, но следует знать, что боль обычно беспокоит ниже пупка.
- Боль может возникать во время еды, поэтому ребенок отказывается продолжать кушать. Иногда боли возникают спонтанно, при этом они совершенно не связаны с приемом пищи.
- Ребенок может жаловаться на тошноту, а когда количество червей зашкаливает, возникает рвота. При этом в рвотных массах можно заметить маленьких белых червячков остриц.
- Расстройства стула абсолютно не связаны с питанием. Возникают то запоры, то диареи.
- Дети плохо и беспокойно спят, зуд в заднем проходе приводит к постоянному расчесыванию.
- Дети, зараженные острицами, подхватывают простуду гораздо чаще, чем их здоровые сверстники.
- Бруксизм у детей считается признаком любой глистной инвазии. Но связь между скрежетом зубов и наличием глистов в организме детей не была доказана.
- Насморк и конъюнктивит также могут стать симптомом гельминтоза, особенно, если лечение медицинскими препаратами не вызывает улучшения состояния.
- У девочек зуд может наблюдаться в области половых органов. Это происходит из-за того, что глисты попадают во влагалище.
- Дети с глистами отстают в развитии от своих сверстников.
- Меняется консистенция стула он становится кашицеобразным, с прожилками слизи.
- Зуд приводит к расчесам, а это может стать причиной воспалительного процесса в кожных складках. Кожные дерматиты, аллергические реакции практически всегда возникают у маленьких детей при энтеробиозе.
- Страдает детская психика. Постоянное ухудшение здоровья приводит к приступам агрессии и раздражительности.
Более детально о симптомах остриц у детей.
Осложнения энтеробиоза при отсутствии лечения
При многократном инфицировании острицами и продолжительном энтеробиозе у больного могут наблюдаться сильные осложнения, такие как:
- головокружение;
- головные боли;
- сильные расстройства ЖКТ;
- понос или запор;
- сильные кожные раздражения, вплоть до появления язв.
Как показали медицинские исследование, при отсутствии лечения энтеробиоза у некоторых людей возникают обмороки. Опасность кожного зуда заключается в том, что человек может расчесать участок кожи, повредить защитный покров и внести вторичную инфекцию, а это уже приведет к нагноению и другим болезням. Как итог, человек попадает в больницу с повышенной температурой и нагноившимися язвами. И только здесь врачи выявляют энтеробиоз и назначают лечение.
Методы диагностики
Лабораторными методами исследования подтвердить энтеробиоз с первого раза практически не удается. Исследование кала бесполезно, так как в него попадают уже мертвые самцы остриц. Используют соскоб с кожи вокруг ануса для выявления яиц гельминта. Чтобы анализ был результативным важно соблюдать несколько правил:
- Сдавать анализ только в утреннее время.
- Гигиенические процедуры перед процедурой запрещены (они уничтожают все признаки пребывания остриц на коже).
- Соскоб лучше делать до дефекации.
В лабораториях практикуют забор материала либо липкой ленты, либо ватной палочкой. Полученный образец сразу же исследуют под микроскопом. При отрицательном результате анализ повторяют еще через неделю. Иногда для выявления паразитов требуется 3-4 соскоба. Косвенным подтверждением глистной инвазии является эозинофилия в клиническом анализе крови.
При энтеробиозе рекомендуют проводить следующие диагностические мероприятия:
- Соскоб проводится с использованием липкой ленты. Человеку необходимо раздвинуть ягодицы, а лаборант в это время приклеит кусочек скотча на кожу вокруг анального отверстия.
Данная процедура проводится с помощью ватной палочки, смазанной вазелином, или липкой ленты, которая клеится на кожу промежности. Мазок берется сразу после пробуждения до посещения туалета без предварительной подготовки.
Взятый материал помещается внутрь герметичной емкости, быстро доставляется в лабораторию. Хранить его можно только несколько часов в холодильнике. Для получения более точного результата соскоб рекомендуется проводить три раза с интервалом в две недели.
2. Мазок можно сделать самостоятельно, а затем отнести в лабораторию для исследований. Для проведения этого метода необходимо приобрести в аптеке специальный диагностический набор. В него входит емкость с герметичной крышкой и палочка, которой необходимо провести после пробуждения вокруг ануса, а затем поместить в емкость и сдать в лабораторию для исследований.
3. Анализ кала позволяет выявить личинок паразита. Проводится несколько раз для получения точных диагностических результатов.
При запущенной стадии заражения визуально остриц можно заметить в каловых выделениях и даже на постельном белье.
После того, как признаки подтвердились медицинским анализом, необходимо начинать лечение острицы. Особенно важно не запускать заболевание, а начинать лечить в первый день.
При обнаружении паразитов хотя бы у одного из членов семьи необходимо провести дегельминтизацию каждому, кто контактирует с заражённым. Для этого фармацевтика выпускает специальные препараты, наиболее эффективные из них пирантел (5-10 мг на 1 килограмм веса), вормил, альбендазол. Чтобы прекратить зуд в анальном отверстии, на ночь ставится содовая клизма: стакан воды и пол-ложки соды. Она вымывает самок червей, предотвращает отложение новых личинок.
Лечение энтеробиоза
Заразиться острицами несложно, но и лечению энтеробиоз поддается достаточно легко. Он считается наименее опасным заболеванием из всех видов паразитарных инфекций. Основной задачей антигельминтной терапии является прерывание шестинедельного жизненного цикла паразитов.
Источником энтеробиоза является человек, поэтому лечить данное заболевание следует комплексно, воздействуя на причины этой глистной инвазии. При появлении внутри семьи зараженного человека лечиться нужно всем. Терапия обязательно происходит на фоне строгого соблюдения правил личной гигиены, поддержания чистоты помещения, дезинфекции санитарных точек.
Лечение важный момент для избавления от гельминтов, не стоит ждать, пока паразиты погибнут самостоятельно за пару недель. Ведь за этот период, даже при соблюдении гигиены, риски повторного заражения крайне велики. Мало того, больной энтеробиозом может заразить всех членов семьи, что в значительной степени затруднит лечение и создаст дополнительные проблемы для окружающих.
Задаваясь вопросом, как лечить острицы у взрослых, не стоит уделять внимание только народным средствам. Врачи, для избавления от энтеробиоза назначают несколько проверенных антигельминтных средств от остриц:
Перед приемом назначенного врачом средства от остриц рекомендуется соблюдать диету в течение суток, согласно которой не рекомендуется употреблять жирную, сладкую или жареную пищу.
Примерно через 2-3 часа, после принятия лекарства, нужно дополнительно выпить сорбент, например смекту или активированный уголь. Дополнительно, через несколько часов потребуется выпить сильное слабительное.
Сразу после первичного приема антигельминтного средства необходимо провести полную уборку всех помещений в доме, перестирать постельное и нижнее белье, а также прогладить их утюгом с двух сторон. Это весьма важный момент, так как на них может быть огромное количество инвазионных яиц, которые могут вновь попасть в организм. Высокие температуры быстро уничтожают яйца остриц.
Во время прохождения курса лечения у больного может начаться сильная аллергия, что возможно при массовой гибели паразитов и интоксикации организма. В таком случае следует дополнительно принимать антигистаминные препараты.
Лекарственные препараты должны назначаться только врачом, после проведенного обследования и анализов, подтверждающих наличие паразитов.
Полноценное лечение проводится в течение месяца, поскольку жизненный цикл этих паразитов составляет 3-4 недели. Если не допустить нового заражения, то за это время острицы погибают даже без лекарственных воздействий. Правильно подобранная схема лечения, медикаменты и народные средства улучшают терапевтический результат.
При глубоком заражении острицами не рекомендуется заниматься самолечением, а лучше обращаться за медицинской помощью. Опытный врач для эффективной терапии детей и взрослых использует одинаковые лекарства, но дозировка и сочетание медикаментозных средств определяется в каждом конкретном случае. Это зависит от веса, индивидуальных особенностей здоровья пациента.
Для большей эффективности лечения не рекомендуется за сутки до приема лекарственных препаратов употреблять в пищу укрепляющие стул продукты.
Среди основных препаратов можно выделить Мебендазол, Пирантел, Левамизол. При тяжелых инвазиях используется Немозол. Этот препарат наряду с сильным антигельминтным действием отличается множеством побочных эффектов. С другой стороны, медикаментозное средство Пиперазин назначают даже в случаях, когда заражаются беременные. Вероятность успешности лечения повышает повторный курс, который рекомендуется провести через две недели.
Также вечером, после приема противоглистных препаратов, следует принять слабительное: Пилокалс, Сенаде. Обязательным условием лечение является повтор курса препаратов спустя 2-3 недели.
При сильном зуде рекомендованы антигистаминные препараты (Цетрин и др).
Больной и его семья должны соблюдать ряд правил гигиены:
- Всегда мыть руки после туалета, перед приемом пищи, после улицы.
- Частая смена нижнего белья (утром и вечером).
- Тщательно проглаживать белье каждый раз после стирки.
- Уборка в квартире (ежедневно, влажная и сухая).
- Подстригать ногти коротко.
Энтеробиоз является достаточно серьезным заболеванием, поэтому необходимо исключить самолечение. Требуется консультация врача и применение индивидуально подобранных терапевтических схем лечения.
https://youtube.com/watch?v=6ylbOu6T38A%3Ffeature%3Doembed
Цикл лечения против остриц отлично дополнят народные средства, которые радикально подавляют жизнедеятельность паразитов.
Среди них можно выделить следующие продукты:
- Чеснок. Этот продукт в виде спиртовых, водных, молочных настоек, как ингредиент многочисленных блюд является непримиримым борцом с энтеробиозом. Любое употребление этого овоща способствует избавлению от остриц.
- Тыквенные семечки. Сырые сушеные семечки в сочетании с молоком, смеси с медом, настойки очень хорошо помогают от глистных инвазий.
- Грибы лисички в любом виде отличное средство от гельминтов, особенно эффективно этот продукт помогает избавиться от остриц.
- Употребление в пищу соленых, кислых продуктов во время цикла лечения делают его более успешным и эффективным. Квашеная капуста, соленые огурцы и их рассолы, лимонный сок полезно употреблять в таких случаях.
Лечение и профилактика остриц у взрослых
Если острицы диагностированы у взрослых, то вполне может быть эффективным лечение в домашних условиях с помощью медикаментозных препаратов. Недостатка подобных лекарственных средств в аптеках сейчас нет. Вот некоторые таблетки от остриц у взрослых:
- Левамизол-декарис;
- Вермокс;
- Мебекс;
- Гельминтокс;
- Телмокс;
- Немозол один из самых сильных противогельминтных препаратов комплексного воздействия, используется при запущенных стадиях заражения, помогает быстро избавиться от остриц.
Какие лучше препараты применить, лучше проконсультироваться у врача. Для повышения эффективности при приеме указанных препаратов следует уделить внимание диете на период лечения и стараться не употреблять продукты, закрепляющие стул, перед сном не перегружать желудок обильной пищей, желательно с утра принимать слабительные средства.
Другим важным фактором успешного лечения будет повторный прием выбранных медикаментов примерно пару недель для уничтожения оставшихся в организме паразитов, так как не все медикаменты работают против личинок и яиц острицы.
При сильно зуде следует принимать антиаллергенные медикаменты ( Цетрин, Супрастин, Злодак). Это поможет также избежать расчесываний и предотвратит попадание яиц паразитов на одежду и предметы окружающей обстановки.
Помимо медикаментозного лечения в этот период необходимо соблюдать и определенные правила гигиены:
- тщательно мыть руки перед приемом пищи, после туалета;
- коротко остригать ногти (чтобы под ними не могли скапливаться яйца гельминтов);
- несколько раз в день менять нижнее белье;
- проводить дезинфекцию постельного белья (стирка и проглаживание горячим утюгом);
- регулярная дезинфекция помещений, особенно туалета.
Соблюдение этих правил поможет вывести острицы у взрослых в кратчайшие сроки и свести к нулю возможность повторного заражения.
В целом, при соблюдении простейшей гигиены, взрослые люди подвергаются подобным заболеваниям не так часто, как дети.
Лечение и профилактика остриц у детей
Как показывают многочисленные статистические исследования подверженность заражению острицами у детей при определенных условиях может составлять 100%. Порой этот процесс принимает характер эпидемии (в основном в детских садах). Но и у детей симптомы заражения острицами не всегда резко проявляются, особенно в начале.
При малейшей жалобе на зуд в области заднего прохода, почесываниях в данной области, нарушениях сна и других, указанных выше, симптомах необходимо сразу же обратиться в медицинское учреждение для диагностики и последующего лечения (при подтверждении заболевания).
Если не начать лечение своевременно, то заболевание может прогрессировать, а отравление детского организма токсинами гельминтов приводить к сильным болям в желудке, сказываться на психическом здоровье и общем состоянии организма ребенка.
Обратите внимание! У девочек дополнительным симптомом может быть недержание мочи (энурез) из за раздражения мочеиспускательного канала.
На первом месте, конечно же, стоит профилактика заболевания. Понятно, что приучить ребенка к регулярному соблюдению правил личной гигиены удается далеко не сразу, но приложенные воспитательные усилия помогут избежать проблем с острицами в будущем.
Важно! При диагностике желательны, а скорей обязательны, повторные анализы, так как острицы не каждую ночь откладывают яйца и не факт, что в собранном материале анализа они будут.
Если все-таки заражение произошло и выявлено, следует немедленно начинать лечение. Подбор нужных медикаментов, дозировка и режим приема осуществляется исключительно врачом! Следует избегать самолечения, чтобы не усугубить заболевание и избежать повторного заражения.
Наиболее часто для лечения детского энтеробиоза применяются следующие лекарственные препараты:
- Левамизол;
- Пиперазин;
- Альбендазол-немозол (уникальное средство от остриц, проявило себя как наиболее сильное лекарство при заражении паразитами, назначается только врачом!);
- Пирантел;
- Мебендазол.
Перед приемом лекарств, необходимо подготовить детский организм надлежащим образом. Избежать сухой, тяжелой мясной пищи, закрепляющих продуктов, отдав предпочтение кисло-молочным вариантам, супам и фруктам. Ужин должен быть очень легким.
Согласно рекомендации врача по дозировке принимать медикаменты по утрам, а вечером дать ребенку слабительное для вывода погибших паразитов из организма. На период лечения необходимо всем членам семьи соблюдать строгие правила гигиены:
- тщательно мыть руки после туалета, перед едой;
- коротко стричь ногти;
- внимательно следить, чтобы больной ребенок не грыз ногти;
- как можно чаще менять нижнее белье ребенку;
- стирать и тщательно проглаживать постельное белье горячим утюгом;
Тщательно проводить дезинфекцию, особенно туалетной комнаты с использование дезинфицирующих средств.
Помимо непосредственно противогельминтных препаратов для смягчения зуда нужно принимать антигистаминные сиропы и капли для детей (например, цетрин, лоратодин), обрабатывать районы воспаления содовым раствором. При сильном зуде показано применение клизмы из раствора соды (половина чайной ложки соды на стакан теплой воды).
Для снятия симптомов токсикоза после гибели паразитов через сутки желательно дать ребенку какой-нибудь энтеросорбент ( активированный уголь, энтеросгель, полифепан и другие). Но, именно через день, чтобы не снизить эффективность основного препарата.
Важно! Курс лечения необходимо повторить через две недели, так как не все паразиты могут погибнуть из-за избирательного воздействия препаратов только на взрослых особей. Важно сообщить о заражении администрации воспитательных и учебных заведений для принятия профилактических и дезинфекционных мер!
Существует несколько известных народных средств для лечения энтеробиоза (в простонародье глистов). Рассмотрим наиболее известные.
Лечение остриц народными средствами в домашних условиях
Наиболее известный природный препарат практикуемый с давних времен тыквенные семечки. В них содержатся вещества, оказывающее пагубное воздействие на паразитов.
Однако, следует помнить, что для лечения и профилактики эффективны только неочищенные семечки! Можно принимать их, как в чистом виде, так и в сочетании с другими продуктами. Например, растолченные плоды с оливковым маслом принимаются натощак за 3 час до приема пищи в течении трех дней. Через пару дней повторить курс приема.
Можно готовить отвары и семян и употреблять натощак с последующим приемом слабительного для вывода погибших паразитов.
Другим народным средством является чеснок, но с его использованием надо быть осмотрительным и не применять при наличии у больного кишечно желудочных заболеваний (гастрита , язва желудка и пр.). Перед сном употребляется несколько измельченных зубчиков чеснока, смешанных с водой, обильно запиваются. Проводить лечение в течении 3 вечеров, через неделю курс повторить.
Также достаточно эффективна смесь лука с подсолнечным маслом и солью, которую следует принимать по столовой ложке перед сном в течении недели. Естественно, с повторением курса через 10 дней.
Можно использовать различные клизмы (например, с раствором варенного чеснока и молоком), для снятия зуда подойдет клизма с небольшим (до 300 грамм) количеством прохладной воды.
Народные средства
Энтеробиоз относится к немногим заболевания, которые можно вылечить в домашних условиях с использованием простых продуктов и народных способов. Приводим самые популярные рецепты:
- Тыквенное семя: самое эффективное народное лекарство от гельминтов. Семечки нужно чистить самостоятельно с сохранением пленки, расположенной сразу под кожурой. 300 г толченых сырых семян смешивают с 100 г меда и съедают за один раз натощак. Затем через несколько часов выпивают слабительное. Эта процедура делается на ночь. Утром можно поставить очистительную клизму.
- Чеснок: два зубчика раздавливают в кашицу и разводят небольшим количеством воды. Полученную смесь выпивают на ночь. Лечение чесноком проводят три дня, через 7 дней курс повторяют.
- Пижма: сухие соцветия (20 г) заливают двумя стаканами молока и добавляют 2 растолченных чесночных зубчика. Смесь нужно прокипятить на медленном огне 10-15 минут, процедить, пить по столовой ложке три раза в день до еды. Пижма имеет противопоказания (беременность, детский возраст, сердечно-сосудистые заболевания), поэтому важно предварительно проконсультироваться с врачом.
- Настойка полыни: ее используют в виде клизмы на ночь. Сухую полынь (столовую ложку) заливают стаканом кипятка, через некоторое время процеживают и остуживают. Клизмы повторяют ежедневно до выздоровления. Отвар можно принимать и внутрь сначала по столовой ложке каждый час, затем временной промежуток между приемами увеличивают постепенно до 6 часов.
- Гвоздика и соль: одна щепотка порошка гвоздики и одна чайная ложка соли разводятся в стакане теплой воды. Пьют эту смесь утром натощак в течение трех дней.
- Репчатый лук с оливковым маслом: лук (100 г) натереть на терке, добавить 50 мл оливкового масла и чайную ложку соли. Выпить перед сном. Курс 5 дней.
- Рассол от квашеной капусты: свежий (не более 1 месяца) рассол пью по стакану утром натощак и вечером после еды. Курс 5 дней.
- Сок свеклы: 100 мл свежевыжатого сока нужно пить утром в течение 14 дней. Важно помнить о сильном послабляющем действии этот средства.
Преимуществом таких способов является их малая токсичность. Это важно при лечении энтеробиоза у беременных, когда большинство традиционных противогельминтных препаратов противопоказано из-за их побочного действия.
Если болен маленький ребенок, можно предотвратить повторное заражение таким способом: ватный тампон смачивается в масле или вазелине и вставляется на ночь в задний проход. Это позволяет предотвратить выход самок наружу для кладки яиц, а также избавляет ребенка от зуда. Конечно, глисты при этом не погибают, но из-за их непродолжительной жизни, через некоторое время организм может очиститься от паразитов даже без лекарств.
Хорошим методом считается лечение чесноком. Перед сном рекомендуется разжевывать зубчик чеснока и запивать его водой. Маленьким детям используют чесночную клизму. Для этого чеснок (2-3 зубка) отваривают в воде и теплым раствором проводят процедуру. Желательно чтобы жидкость задержалась в заднем проходе хотя бы 5-10 мин.
Семена тыквы можно использовать самостоятельно или в сочетании с оливковым маслом. Потребуется 100 г сырых семечек и 100 мл масла. Семена измельчаются и смешиваются с маслом. Смесь принимается в утренние часы натощак. Завтракать можно через 3 часа.
Пижма, полынь, чабрец прекрасные антигельминтные травы. Можно использовать отдельно каждую из них или воспользоваться сбором. Лечение травяными отварами продолжается длительно, рекомендуется проводить очистительные курсы с перерывами между ними. Это позволит вывести не только взрослых паразитов, но и избавит от вновь вылупившихся личинок.
Лекарственные препараты
Если результаты анализа свидетельствуют о присутствии остриц в теле человека, врач назначает лечение. Эффективное быстродействующее средство против данных нематод конечно же есть. А чем лечить острицы у детей? И детям и взрослым обычно прописывается одно и то же лекарственное средство, но в разных дозировках.
Обычно назначают:
- Левамизол-Декарис (стоимость зависит от формы выпуска и составляет в среднем 70 рублей);
- Пирантел (его цена 30-35 рублей);
- Гельминтокс (приблизительно 80-120 рублей);
- Мебендазол (от 90 до 120 рублей);
- Вормин (стоит около 20 рублей);
- Вермокс (около 90 рублей).
Все эти лекарственные препараты отпускаются без рецепта и всегда есть в наличии в любой аптеке.
Назначить также могут Пиперазин данный препарат считается малоэффективным против остриц, однако только его можно принимать во время беременности и лактации. Стоит он около 30 рублей.
Иногда врач назначает Немозол, который относится к сильным противогельминтным средствам, но при этом обладает рядом противопоказаний. Его применение актуально в случае, если помимо остриц обнаружены другие виды глистов. В других же ситуациях отлично подойдут более мягкие средства. Стоимость препарата около 180 рублей.
Любое лечение будет эффективным лишь в том случае, если приём лекарства повторить через две недели. Это указано в инструкции, это обязательно говорит врач. Вызвана данная необходимость тем, что на личинки и яйца действующее вещество препарата не влияет только на взрослых особей. Через две недели оставшуюся популяцию можно будет полностью уничтожить.
Если приём препаратов вызывает сильный зуд, врач может прописать антигистаминные средства к примеру, Цестрин, Зодак, Лоратодин. Облегчить зуд можно при помощи специальной клизмы. Для её приготовления необходимо растворить 10 грамм пищевой соды в литре воды.
Обязательный элемент лечения нововведения в сфере личной гигиены. Важно:
- мыть руки с мылом после туалета, перед едой, после прогулки;
- коротко подстричь ногти;
- менять нижнее бельё утром и вечером;
- сразу стирать, пропаривать утюгом;
- ежедневно в квартире надо делать влажную уборку, дезинфицировать туалет.
Эти несложные процедуры помогут избавиться от паразитов, снизить риск инвазии окружающих.
Медикаментозное лечение
Назначение медикаментов происходит только после постановки точного диагноза, исходя из клинической картины и лабораторных исследований. Для терапии энтеробиоза требуется комплексный подход, который поможет не только избавиться от паразита, но и восстановить организм, убрать сопутствующие негативные симптомы.
Обычно антигельминтная терапия сопровождается приемом:
- седативных средств для устранения аллергических реакций;
- сорбентов помогут вывести токсины из организма;
- витаминные комплексы и иммуностимуляторы направлены на быстрый реабилитационный период, укрепление иммунной системы, восстановление поврежденных паразитом органов;
- в некоторых случаях для подавления негативной симптоматики используют народные рецепты.
Важно отметить народные способы лечения энтеробиоза являются лишь дополнением к основной терапии и должны быть согласованы с лечащим врачом.
Любые методы лечения имеют ряд противопоказаний, при игнорировании которых развиваются побочные эффекты, значительно ухудшающие самочувствие и осложняющие процесс выздоровления!
Обычно для терапии остриц назначают:
| Препарат | Описание |
| Пирантел | Выпускают в виде таблеток, суспензий. Оказывает парализующее действие на паразита, из-за чего он больше не может крепиться к кишечнику и выводиться из него во время дефекации. |
| Пиперазин | Эффективное средство, которое приводит к параличу червей. Воздействует как на взрослых особей, так и на их яйца. Дозировка назначается исключительно лечащим врачом. |
| Декарис | Препарат широкого спектра действия с выраженными иммуномодулирующими свойствами. Противопоказан для детей младше 3 лет, при беременности и грудном вскармливании. |
| Мебендазол | Негативно сказывается на метаболических процессах паразита, тем самым убивая его. Не всасывается в организме, практически весь выходит из него в течение суток. Прием медикамента может сопровождаться определенными побочными эффектами.
Арсенал антигельминтных препаратов разнообразен. Острицы чувствительны к большинству из них, поэтому медикаментозное лечение энтеробиоза не представляет сложности. Общим их недостатком является токсичность, за счет которой возникают частые побочные явления и имеются противопоказания (беременность, многие хронические заболевания). Рассмотрим основные лекарства, которые помогают избавиться от паразитов:
Для большей эффективности накануне лечения рекомендуют принимать легкую пищу, исключить все закрепляющие продукты. Вечером в день приема таблетки желательно выпить слабительное или поставить очистительную клизму. Тогда избавление от паразитов будет более быстрым. Через 2 недели процедуру повторяют, так как лекарственные средства действуют только на взрослых особей, а из оставшихся яиц может возникнуть новая популяция глистов. |
Профилактика
Инвазия острицами часто абсолютный сюрприз. Однако в этом нет ничего удивительного. Увы, заразиться острицами можно в любой момент. Снизить риск инвазии помогут полезные привычки обязательно мыть руки с мылом перед приёмом пищи и после посещения туалета.
Когда один из членов семьи заболел, обезопасить близких, предотвратить распространение гельминтов поможет: ежедневная смена постельного белья, нижнего белья, одежды. Их необходимо стирать каждый день, при максимально допустимой температуре. После стирки желательно прогладить.
Эффективной мерой предосторожности является использование собственного набора посуды. Её следует тщательно мыть, дополнительно обливать кипятком. Бытовые предметы, с которыми пациент контактирует, надо каждый день мыть в мыльном растворе. Это касается и детских игрушек. При этом надо учитывать, что мыльный раствор намного эффективнее препятствует распространению остриц, чем другие средства.
Домашние животные не могут сами заразиться острицами и всё же яйца этого вида гельминтов легко попадают на шерсть, к примеру, долгое время остаются на ней. Контакт больного с питомцами надо свести к минимуму. После контакта, следует тщательно мыть руки с мылом.
Основным фактором предотвращения заболеваний (особенно у детей), связанных с паразитами является прежде всего профилактика! Заключается она не только в соблюдении правил личной гигиены, но также в информировании родителей, детей и остальных граждан о способах предотвращения заражения, путях передачи возбудителей, последствиях заболеваний и способах лечения. Для этого следует использовать все возможные средства информации, от личных бесед и лекций до передач по телевидению, радио, интерактивных программ и интернета. Также необходимо взять во внимание следующие рекомендации:
При возникновении очага инфекции важной мерой против распространения остриц является санитарная обработка помещения. Особенно это актуально для детских учреждений, больниц, где подобные мероприятия проводятся под контролем соответствующих служб.
Дезинфекции подвергаются унитазы, дверные ручки, стены и перегородки в туалете. Постельное белье, скатерти, полотенца подлежат кипячению. Дома тщательной обработке подвергаются мягкие игрушки, ковры. Квартиру нужно хорошенько пропылесосить, после чего мешки для мусора сжечь.
Постельное и нижнее белье больного необходимо тоже продезинфицировать, проглаживая после стирки горячим утюгом. При термической обработке исключается повторное заражение острицами. Учитывая, что паразиты могут передаваться через личные вещи, рекомендуется каждому члену семьи иметь свои постельные принадлежности и полотенца.
Чтобы не заразиться острицами, следует выполнять следующие требования:
- Мыть руки с мылом как можно чаще: после прогулок, походов по магазинам, поездок в транспорте. Необходимо умываться, подмываться утром и вечером с использованием мыла или геля.
- Детский энтеробиоз способен доставить массу проблем всем членам семьи. Поэтому при выявлении глистов у малыша переходят к усиленной уборке в доме. Полы моют ежедневно с любым дезинфицирующим средством. Посуду кипятят. Столы протирают с дез.препаратами.
- Белье ребенка кипятят, постельные принадлежности также стирают ежедневно. Затем вещи проглаживают утюгом.
- Ковры, на которых ползает ребенок, обрабатывают пароочистителем или проглаживают через марлю утюгом.
- Игрушки обдают кипятком, мягкие игрушки стирают в машинке при высокой температуре. Если игрушка не помещается в машинку, ее проглаживают горячим утюгом.
- Все овощи и фрукты тщательно моют перед подачей на стол.
- Животных обязательно глистогонят каждый квартал. После общения с питомцами тщательно моют руки.
Несоблюдение правил приводит к повторному заражению и симптомы энтеробиоза усиливаются. Зуд может беспокоить постоянно, это связано с увеличением числа паразитов.
Даже если глисты были выявлены только у ребенка, всем остальным также необходимо стирать и менять белье ежедневно, до полного избавления от паразитов. Это позволит предупредить повторное заражение. Для подтверждения отсутствия глистов, сдают 2-3 анализа с промежутком между ними 7-10 дней.
Видео педиатра доктора Комаровского об энтеробиозе + советы Комаровского по лечению от остриц у детей:
https://youtube.com/watch?v=OsxlzByUs90%3Ffeature%3Doembed
В настоящее время количество заболеваний, связанных с заражениями острицами (и другими паразитами) существенно снизилось, но тем не менее случаются периодические вспышки. Связаны они прежде всего с несоблюдением элементарных норм гигиены. Устранение этих недостатков и проведение систематической профилактической работ, особенно в детских образовательных учреждениях позволит снизить уровень заболеваемости паразитами еще больше.
Профилактика традиционными домашними средствами
Часто предотвратить размножение глистов в кишечнике или снизить вероятность заражения помогают простые профилактические средства. Большинство из них не имеет побочных эффектов, поэтому их можно принимать даже детям в умеренных количествах. К таким средствам относятся:
- лук и чеснок;
- земляника;
- морковь;
- гранат;
- грецкие орехи;
- отвар зверобоя (принимать с осторожностью).
Оградить себя от потенциально опасных паразитов может каждый. В случае заражения обратитесь к врачу. Он установит правильный диагноз и назначит лечение.
Как выглядят острицы при колоноскопии
Если соскоб в области ануса часто дает ложноотрицательные результаты, то колоноскопия визуальный осмотр слизистой оболочки толстого кишечника, всегда подтверждает диагноз энтеробиоза. На видео представлены половозрелые особи остриц, обнаруженные при эндоскопическом обследовании толстой кишки.
https://youtube.com/watch?v=AiZdyrTnW7s%3Ffeature%3Doembed
Колоноскопия сложная процедура, которая с трудом переносится пациентами. Но бывают случаи, когда диагностику энтеробиоза нужно провести срочно, не дожидаясь массивного заселения паразитами кишечника. Тогда этот метод незаменим и дает 100% результаты.
Заключение
Энтеробиоз нельзя отнести к тяжелым глистным инвазиям. Паразиты имеют относительно небольшие размеры, интоксикация организма в результате их жизнедеятельности средняя. Но легкомысленно относиться к этой проблеме нельзя.
Запущенные формы заболевания протекают тяжело, вызывают осложнения (кишечные кровотечения, бактериальное воспаление тканей перианальной области, нарушение пищеварения и дисбактериоз). Самая большая проблема быстрое распространение паразитов и трудности лабораторной диагностики. Появление даже незначительного зуда в области заднего прохода, который усиливается ночью, требует немедленного обращения к врачу для исключения поражения острицами.
Вопрос-ответ
Как понять, что у тебя острицы?
Зуд, расчесы, сопровождающие выползание остриц на кожуРасчесывание кожных покровов провоцирует распространение яиц остриц и повторное самозаражение, вследствие которого заболевание может продолжаться длительное время. Аллергическая реакция, сыпьРаздражение, плаксивость, беспокойный сонЕщё
Чем можно убить остриц?
Энтеробиоз (вызывается острицами) Яйца остриц достаточно жизнеспособны во внешней среде, чувствительны не ко всем дезинфицирующим средствам, но быстро погибают от кипячения и действия ультрафиолета.
Откуда острицы у взрослых?
Патофизиология инвазия остриц Заражение обычно происходи вследствие перемещения яиц из перианальной области на предметы (одежду, постельные принадлежности, мебель, коврики, игрушки, туалетные сидения), откуда они подбираются новым хозяином, попадают в рот и проглатываются.
Через сколько дней после заражения появляются глисты?
Первые симптомы энтеробиоза появляются через две недели после заражения. За это время из попавших в кишечник глистных яиц «вылупляются» маленькие острицы и растут до половозрелой особи. А дальше у них начинается размножение. Тяжесть заболевания, кроме всего прочего, зависит еще от количества проглоченных паразитов.
Советы
СОВЕТ №1
Регулярно мойте руки с мылом, особенно после посещения туалета и перед едой. Это поможет предотвратить распространение остриц и снизит риск заражения.
СОВЕТ №2
Соблюдайте правила личной гигиены. Меняйте постельное белье и одежду как минимум раз в неделю, а также стирайте их при высокой температуре, чтобы уничтожить возможные яйца остриц.
СОВЕТ №3
Обратите внимание на диету. Употребление продуктов, богатых клетчаткой, может помочь улучшить работу кишечника и снизить вероятность заражения острицами.
СОВЕТ №4
Если вы подозреваете, что вы или ваши дети могли заразиться острицами, обратитесь к врачу для диагностики и лечения. Чем раньше начнется лечение, тем быстрее вы сможете избавиться от проблемы.